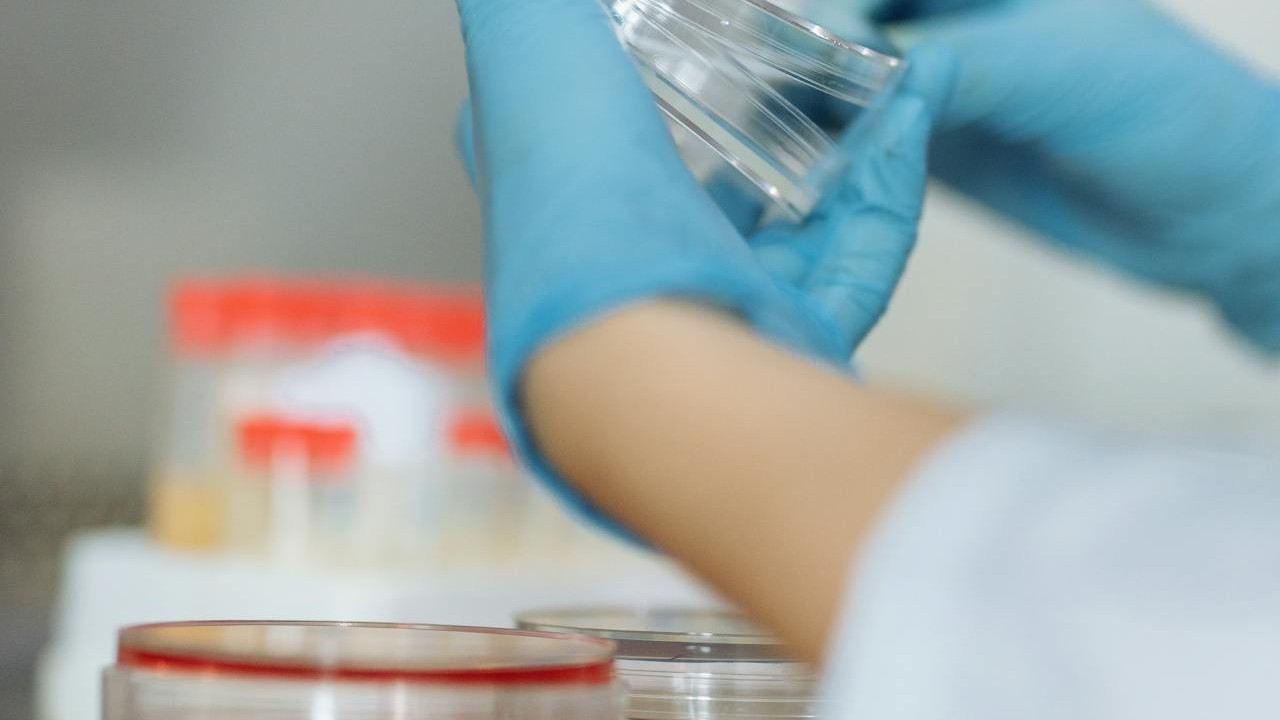

mRNA-Therapie bei CF: Aktuelle Studie untersucht neuen Ansatz
Nicht alle Menschen mit Cystischer Fibrose (CF) können von CFTR-Modulatoren profitieren – etwa aufgrund seltener CFTR-Varianten oder weil die Medikamente nicht vertragen werden. Für diese Betroffenen werden neue Therapieansätze besonders intensiv erforscht. Ein aktuelles Forschungsprojekt aus Deutschland untersucht nun, ob eine mRNA-basierte Therapie künftig eine zusätzliche Behandlungsoption darstellen könnte.
Veröffentlicht am 13. April 2026
Im Zentrum steht die Frage, ob körpereigene Lungenzellen durch die Inhalation von CFTR-mRNA dazu angeregt werden können, selbst einen funktionierenden CFTR-Kanal zu bilden. Damit würde direkt an der Ursache der Erkrankung angesetzt: dem gestörten Salz- und Wassertransport auf der Oberfläche der Atemwege.
Die Arbeitsgruppe um Josef Rosenecker am LMU Klinikum München erforscht diesen Ansatz aktuell im Labor. Dabei wird künstlich hergestellte CFTR-mRNA gezielt über die Atemwege inhaliert, sodass sie direkt in die Zellen der Lunge gelangen soll. Dort dient sie als Bauanleitung, damit die Zellen das fehlende CFTR-Protein selbst herstellen können.
Frühere Studien zeigten, dass die grundsätzliche Idee funktioniert, die klinische Wirksamkeit jedoch bislang begrenzt war. Eine zentrale Herausforderung liegt darin, die mRNA effizient und verträglich in die Zielzellen der Atemwege und des Lungengewebes zu transportieren. Genau hier setzt das aktuelle Projekt an: Die Forschenden arbeiten mit neu entwickelten Transportsystemen auf Basis sogenannter Nanopartikel, die eine gezieltere Abgabe der mRNA ermöglichen sollen.
In der laufenden Studie wird nun untersucht, ob diese Methode dazu führt, dass ausreichend CFTR-Protein in den Zellen gebildet wird. Die Tests erfolgen zunächst im Labor und anschliessend in Tiermodellen, unter anderem ebenfalls über eine Vernebelung der mRNA, also eine inhalative Anwendung. Ziel ist es, die Grundlage für spätere klinische Studien zu schaffen.
Ein grosser Vorteil dieses Ansatzes: Eine mRNA-Therapie wäre unabhängig von der individuellen Mutation und könnte somit grundsätzlich allen Menschen mit CF zugutekommen – auch jenen, die heute keine wirksame Therapieoption haben. Gleichzeitig ist zu beachten, dass eine solche Behandlung voraussichtlich regelmässig wiederholt werden müsste, da mRNA im Körper nach einiger Zeit abgebaut wird.
Aktuell befindet sich die Forschung noch in einer frühen, präklinischen Phase. Eine Anwendung im klinischen Alltag ist daher kurzfristig nicht zu erwarten. Dennoch zeigt das Projekt eindrücklich, wie intensiv weltweit an neuen Therapieansätzen für CF gearbeitet wird – auch für jene Patientinnen und Patienten, für die bestehende Behandlungen nicht ausreichend sind.
Die Inhalte dieser News basieren auf einem Beitrag von Mukoviszidose e. V. (Deutschland). Die Veröffentlichung erfolgt mit entsprechender Zustimmung.
Den vollständigen Artikel können Sie hier lesen.


